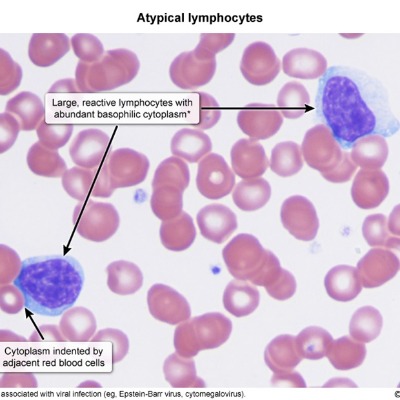

Activity
Mon
Wed
Fri
Sun
Jul
Aug
Sep
Oct
Nov
Dec
Jan
Feb
Mar
Apr
May
Jun
What is this?
Less
More
Memberships
Accelerator
9k members • Free
Contributions
@aleem-siddiqui
I help people overcome weight loss pleateaus and achieve their ideal weight with my fat shredding program
Active 486d ago
Joined Oct 15, 2020
Powered by